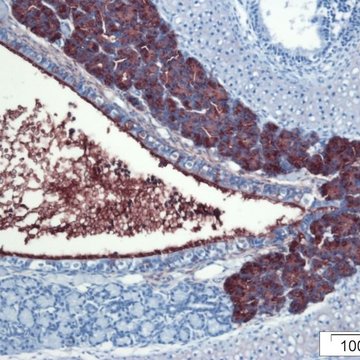
Lecture: A head full of PLUNCs: What is driving functional diversity in the BPIF/PLUNC gene family?

MICOBION
Lecture: A head full of PLUNCs: What is driving functional diversity in the BPIF/PLUNC gene family?
Prof. Colin D Bingle
Professor of Respiratory Cell and Molecular Biology, Department of Infection, Immunity & Cardiovascular Disease, The Medical School, University of Sheffield
Tuesday, March 12th 2019, 15:00
BIOCEV Conference Hall











































